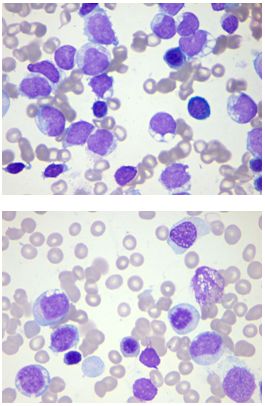

急性髓系白血病伴CEBPA双等位基因突变1例
病例简介:
患者,女,27岁,主因“间断性双下肢皮肤紫癜3月余,咳嗽、咳痰、发热5天”就诊。患者于入院前3月余无明显诱因出现双下肢皮肤紫癜,5天前患者受凉后出现间断性发热,体温最高39℃,伴有咳嗽、咳痰,就诊于当地私人诊所,给予抗感染治疗(具体不详),患者无明显缓解,并逐渐出现牙龈渗血、肿痛,左侧下颌部淋巴结肿大,遂前往当地市医院就诊,查血常规示:WBC 8.0×109/L,NE 5.0%(↓),LY 93.7%(↑,仪器分类),HGB 75g/L(↓),PLT 36×109/L(↓)。遂来我院就诊,门诊以“血细胞异常待查”收住我院血液科。
查体:T 36.8℃,贫血貌,神志清楚,精神欠佳,全身皮肤及粘膜无明显苍白,双下肢散在出血点及紫癜。左侧下颌部可触及约1×2cm大小淋巴结。口唇及甲床苍白。双肺叩诊呈清音,听诊呼吸音粗,未闻及干湿性啰音及胸膜摩擦音。肝、脾肋下未触及。
实验室检查:
血常规:WBC 6.71×109/L,NE 1.8%(↓),LY 57.4%,MO 40.5%(↑,仪器分类),RBC 2.63×1012/L(↓),HGB 58g/L(↓),MCV 76.8fL(↓),MCH 22.1pg(↓),MCHC 287g/L(↓), PLT 35×109/L(↓)。血涂片镜下复检:可见较多原、幼单核细胞。
凝血+纤溶功能检测结果:PT 11.6s,INR 0.97,APTT 38.1s(↑),TT 16.9 s,Fbg 2.97g/L;D-dimer 0.42mg/L,FDP 1.80μg/mL,AT3:C 63.9%(↓)。
贫血五项:血清铁 4.05μmol/L(↓),铁蛋白 16.70ng/mL(↓),叶酸 20.05 nmol/L,维生素B12 189.0pmol/L,EPO 19.82mIU/ml(↑)。
外周血片所见如下:

骨髓涂片所见如下:

骨髓活检结果如下:

染色体核型分析结果如下:

NPM1基因突变检测结果如下:

CEBPA基因突变检测结果如下:

综合诊断结论:
文献复习:
急性髓系白血病(acute myeloid leukemia,AML)是一组异质性很强的恶性血液系统肿瘤,不同患者的形态学、免疫学、细胞遗传学、分子生物学和临床表现差异很大。目前对白血病的研究和应用已进入了“突变组”时代,基因突变检测可以指导临床对AML患者进行精确分层诊断、预后评估、靶向治疗或更合适的化疗方案的选择[1]。2016年WHO造血和淋巴组织肿瘤重新修订了AML的分型,已将AML伴CEBPA双等位基因突变列为独立的具有重现性细胞遗传学异常AML亚型之一。重现性细胞遗传学异常和基因突变进行整合能够提高AML的预后价值,从而确立了基因突变在AML预后中的重要性[1]。
白血病中常见的基因突变按功能主要可分为3类:I类主要指激酶通路信号转导分子突变,为细胞提供增殖优势;II类主要为转录因子突变,导致细胞的分化和凋亡异常;Ⅲ类主要为表观遗传调控分子突变,可使多种基因表达调控异常、细胞分化和功能紊乱。王芳[1]等的研究显示:各种基因突变在初诊AML患者中的发生频率由高到低依次为CEBPA、FLT3、NPM1、TET2、KIT、DNMT3A、PHF6、IDH1、IDH2、ASXL1;按检测到的突变数计算,最常发生突变的基因依次是CEBPA、FLT3-ITD、NPM1和TET2,所有基因均存在与其他一种或多种基因同时发生突变的情况。
CEBPA基因位于染色体19q13,编码一个长为356个氨基酸残基的蛋白质,属于髓系特异性的碱性区域/亮氨酸拉链(bZIP)家族,是维持造血系统粒系增殖与分化平衡的重要转录因子。研究发现CEBPA突变绝大多数见于AML,占AML的6%~15%,占标危组AML的15%~18%,多见于FAB分型的M1或M2,多数同时具有N端和C端双侧突变,且分布在不同的等位基因上。研究显示,CEBPA基因突变(尤其CEBPA双等位基因突变)是正常核型AML患者预后好的指标,其CR率、DFS率及OS率均明显优于无突变者,且CEBPA基因双侧突变患者才具有良好预后,而单侧突变与无突变患者预后大致相当,但其预后意义还受共同存在的FLT3-ITD等其他基因突变的显著影响,显示同时进行多种基因突变检测的重要性[1-2]。Kurosawas等发现在AML化疗缓解后期,CEBPA双等位基因突变患者预后较好,支持继续化疗,而CEBPA单等位基因突变或野生型患者预后差,化疗缓解后需行自体干细胞移植(auto-HCT)。Ahn JS等的一项多因素分析发现CEBPAdm是AML获得完全缓解后的一项预后较好独立危险因素,40个月的随访资料发现CEBPAdm与CEBPA野生型相比,其OS、EFS较高,RI较低;完全缓解后CEBPAdm组巩固化疗较auto-HCT组重要,auto-HCT组的EFS和RI较低,非复发死亡率较高,但两组的OS无显著差异。我国的相应研究也发现了CEBPA突变的CR、OS较高,预后较好,同时伴有高WBC计数和Hb,CD7和HLA-DR高表达,CD34和CD56低表达。Lavallée和Maxson等的研究均表明CEBPA突变与JAK-STAT通路调控因子继发突变高度一致,尤其是粒细胞集落刺激因子3受体(CSF3R)突变,因此针对CEBPAdm患者的JAK-STAT通路抑制剂的靶向治疗已进入临床试验[2]。
参考文献:
[1] 王芳,张阳,陈雪,等. 初诊急性髓系白血病患者十种常见突变基因的突变组分析[J]. 白血病•淋巴瘤,2015,24(3):161-164.
[2] 喻雕,胡兰,周涛. 急性髓细胞白血病基因突变对预后的影响[J]. 吉林医学,2017,38(8):1568-2570.
检验视界网微信平台独家首发,转载请注明来源及作者!

